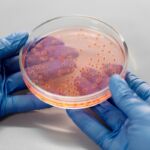

Γρεβενιώτες Κοζάνης σε πανηγυρικό γλέντι στην Καλλιθέα της πόλης των Ιωαννίνων

Ο Σύλλογος Γρεβενιωτών Κοζάνης Ο ΑΙΜΙΛΙΑΝΟΣ μετά από πρόσκληση του Πολιτιστικού Συλλόγου Η ΚΑΛΛΙΘΕΑ Ιωαννίνων, συμμετείχε με τμήμα του χορευτικού του τμήματος στο 2/μερο πανηγυρικό γλέντι την πρώτη μέρα 29 Ιουνίου στην πλατεία της Καλλιθέας.
Η εκδήλωση ξεκίνησε με πατινάδα μετά τον εσπερινό από τον Ιερό Ναό Αγίου Σεραφείμ και Αγίων Δώδεκα Αποστόλων μέχρι την κατάμεστη πλατεία από κόσμο όπου και πραγματοποιήθηκε το γλέντι.
Το Δ.Σ. του Συλλόγου Γρεβενιωτών Κοζάνης ευχαριστεί θερμά τον Πολιτιστικό Σύλλογο Η ΚΑΛΙΘΕΑ τόσο για την τιμητική πρόσκληση στις πανηγυρικές τους εκδηλώσεις όσο και για την θερμή υποδοχή και εξυπηρέτηση που παρείχε σε όλα (4 συνολικά) χορευτικά τμήματα.
Ο Πρόεδρος: Λότσιος Αθανάσιος
Ο Γ. Γραμματέας: Ντάγκας Νικόλαος